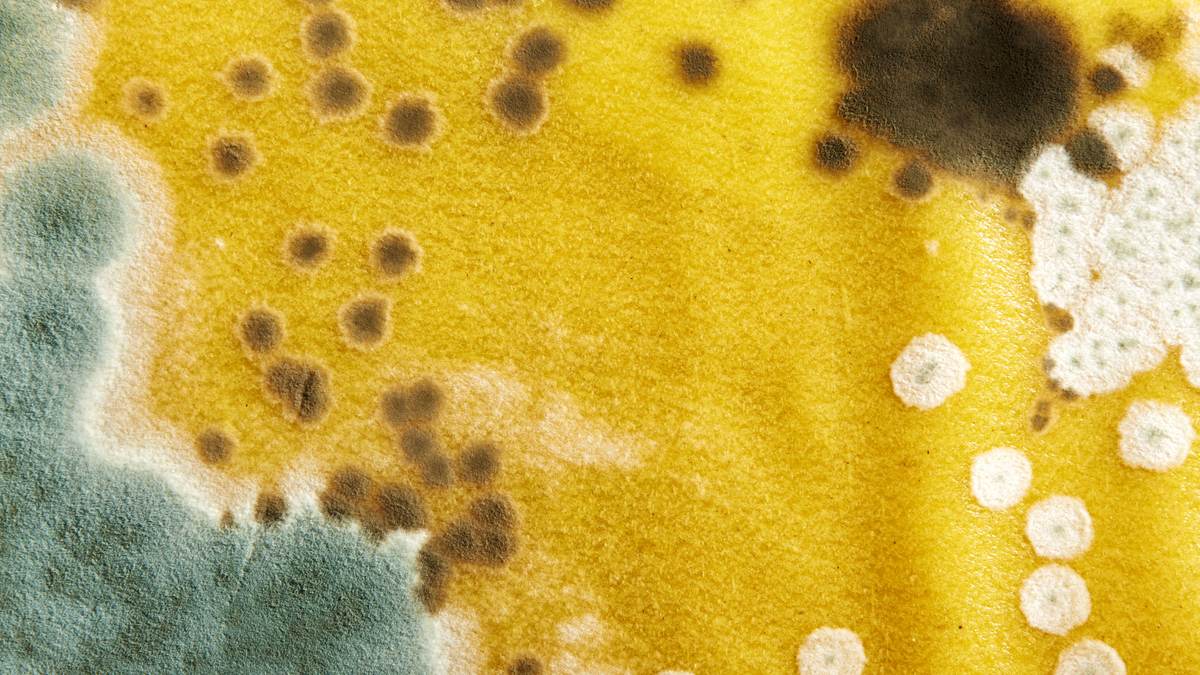

CategoriesDiet & Exercise
Discover More Articles
It’s no secret that stress can take a toll on our body, mind, and brain. December is not the month to throw your self-care and mental health priorities out the window.
5 Ways to Stay Motivated This Winter
When the seasons change it suddenly becomes harder to get out and exercise. Winter fitness programs aren’t the easiest to stick to, but they’re imperative to your overall health and well-being. So with that in mind, let’s take a look at what you can do to stay motivated and successful with your winter fitness goals.
How to Detox After Holiday Feasts
If you’re having a hard time committing to your diet over the holidays, you’re not alone. And the good news is you don’t have to be perfect to maintain your weight over the holiday season. Try following these simple detox tips after each scrumptious holiday meal and start the new year fresh and ready to finally achieve your health and fitness goals.
High Protein Meal Replacement Shakes
Meal replacement shakes aren’t just low in calories, they’re high in essential nutrients your body needs to keep yourself nourished and your stomach feeling full, while helping also you maintain or lose weight. Protein provides numerous benefits to your body, including fueling the entire body, helping build muscle mass and being a key component to essential substances your body needs, like antibodies and blood.
Skin Cycling: all about the newest trend
The skin cycling hashtag has been viewed over 3 billion times on TikTok—and dermatologists say it's a strategy worth trying.The term "skin cycling" is all about taking a cyclical approach to your facial skincare routine.
Get ready for a plumper, perkier-looking neckline
Meet our new luscious neck cream featuring our proprietary elasticizing bioactive plant blend that targets lines and texture, so your neckline appears smoother, renewed & 10 years younger looking!
TRENDING MAKEUP HACK: BLUSH & BRONZER AS EYESHADOW
By selecting shades that complement each other, you can achieve a harmonious and polished makeup look without the need for multiple products.
5 signs you need more electrolytes
Electrolytes help with hydration by ensuring the body can actually absorb and use the water you drink—preventing dehydration in the presence of sufficient water intake.
Ring In 2025 With ✨ Glowing ✨ Skin…And FREE Boosters!
Better Ingredients, Better You
Your health goals aren’t one-size-fits-all, so your supplements shouldn’t be either. That’s why we designed the Power Line to target different pillars of performance and wellness — from appetite control to anti-aging to athletic power.